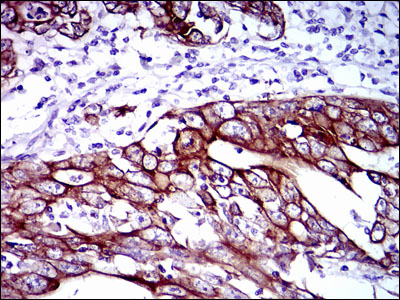
Immunohistochemical analysis of paraffin-embedded stomach cancer tissues using CK5 mouse mAb with DAB staining.

-
Product Name
Anti-Cytokeratin 5 (6G5) Mouse antibody
- Documents
-
Description
Cytokeratin 5 (6G5) Mouse monoclonal antibody
-
Tested applications
WB, IHC-P, ICC/IF, FC
-
Species reactivity
Human, Mouse, Monkey
-
Isotype
Mouse IgG1
-
Preparation
Antigen: Purified recombinant fragment of human CK5 expressed in E. Coli.
-
Clonality
Monoclonal
-
Formulation
Purified antibody in PBS with 0.05% sodium azide
-
Storage instructions
Store at 4°C short term. Store at -20°C long term. Avoid freeze / thaw cycle.
-
Applications
WB: 1/500 - 1/2000
IHC: 1/200 - 1/1000
ICC: 1/200 - 1/1000
FC: 1/200 - 1/400
ELISA: 1/10000
-
Validations

Flow cytometric analysis of HeLa cells using CK5 mouse mAb (green) and negative control (red).

Immunohistochemical analysis of paraffin-embedded breast cancer tissues using CK5 mouse mAb with DAB staining.

Immunofluorescence analysis of HeLa cells using CK5 mouse mAb (green). Red

Western blot analysis using CK5 mouse mAb against A431 (1), MCF-7 (2), HeLa (3), HepG2 (4), 3T3-L1 (5), and COS-7 (6) cell lysate.
Immunohistochemical analysis of paraffin-embedded stomach cancer tissues using CK5 mouse mAb with DAB staining.

Western blot analysis of extracts from A549,MCF7,C6 and Hela cell lysates using Keratin 5 mouse mAb (1:2000 diluted).Predicted band size:62KDa.Observed band size:62KDa.

Immunofluorescence analysis of HeLa cells. Blue
-
Background
Swiss-Prot Acc.P13647.The protein encoded by this gene is a member of the keratin gene family. The type II cytokeratins consist of basic or neutral proteins which are arranged in pairs of heterotypic keratin chains coexpressed during differentiation of simple and stratified epithelial tissues. This type II cytokeratin is specifically expressed in the basal layer of the epidermis with family member KRT14. Mutations in these genes have been associated with a complex of diseases termed epidermolysis bullosa simplex. The type II cytokeratins are clustered in a region of chromosome 12q12-q13.
Related Products / Services
Please note: All products are "FOR RESEARCH USE ONLY AND ARE NOT INTENDED FOR DIAGNOSTIC OR THERAPEUTIC USE"
